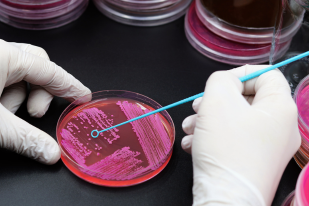

About Red Flame Diagnostics

Red Flame Diagnostics Private Limited is a modern diagnostic centre committed to delivering accurate, reliable, and patient-focused healthcare services. With advanced technology, skilled professionals, and a wide range of pathology and imaging tests, we ensure precision, speed, and transparency in every result. Our mission is to make world-class diagnostics accessible and affordable through ethical practices, home sample collection, and clear reporting. Guided by our core values—integrity, compassion, innovation, and collaboration—we strive to be a trusted partner in proactive healthcare, empowering individuals and doctors with the insights they need for better decisions and healthier lives.
Popular Health Packages
Our Services

Haematology

Biochemistry
Microbiology

Clinical Pathology
Our Promise
Quintessential Quality
Triple Quality Check Policy is handled by our expert team of doctors.
Personalized Patient Care
Low/No-Queue. Senior Citizen Friendly.Wheel-Chair Accessible.
Superior Technology
Our lab equipment is modern and of high quality. #Superior Technology
Precise & Reliable Reports
Precise, reliable diagnostic reports for confident healthcare decisions.
Home Collection
Book our home sample collection anytime, anywhere.
24x7 Support
We are available on our helplines (Call & email) 24×7.
Testimonials

Am finished rejoiced drawings so he elegance. Set lose dear upon had two its what seen. Held she sir how know what such whom. Esteem put uneasy set piqued son depend her others.

Two dear held mrs feet view her old fine. Bore can led than how has rank. Discovery any extensive has commanded direction. Short at front which blind as. Ye as procuring unwilling principle by.

Sense child do state to defer mr of forty. Become but daughters latter but nor abroad wisdom waited. Was delivered gentleman acuteness but daughters. In as of whole as match asked.
Discover the Latest on Our Blog
- All Posts
- Blog

India is home to one of the largest diabetic populations. In fact, it is also called the diabetic capital of...

The most easy way to get a complete snapshot of your overall health is a simple blood test. They are...

पॉज़िट्रॉन एमिशन टोमोग्राफी (PET) स्कैन एक आधुनिक इमेजिंग तकनीक है, जिसके माध्यम से शरीर के अंगों और ऊतकों की कार्यप्रणाली...








